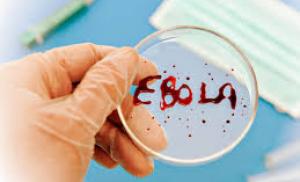
Эбола

Если вы гордитесь своими многофункциональными способностями, то знайте, что фокусировка внимания лишь на одном экране более благоприятно влияет на Ваш мозг
Если вы гордитесь своими многофункциональными способностями, то знайте, что фокусировка внимания лишь на одном экране более благоприятно влияет на Ваш мозг
 Вы считаете, что способны отлично улавливать информацию попеременно переводя взгляд с монитора компьютера на экран гаджета (например, смартфона) и обратно?...
Вы считаете, что способны отлично улавливать информацию попеременно переводя взгляд с монитора компьютера на экран гаджета (например, смартфона) и обратно?...
 В зимнюю погоду Ваша кожа может стать такой же сухой, как климат в пустыне Сахара. Подготовьтесь к зиме, просто изменив ежедневную методику ухода за кожей.
В зимнюю погоду Ваша кожа может стать такой же сухой, как климат в пустыне Сахара. Подготовьтесь к зиме, просто изменив ежедневную методику ухода за кожей.
 Если Вы пользуетесь косметическими продуктами...
Если Вы пользуетесь косметическими продуктами...
 Пение в коллективе делает человека счастливым
Пение в коллективе делает человека счастливым
 Пойте в коллективе, оказывается, как и многие другие виды деятельности, пение приносит гораздо большее удовольствие, если вы наслаждаетесь им в обществе других...
Пойте в коллективе, оказывается, как и многие другие виды деятельности, пение приносит гораздо большее удовольствие, если вы наслаждаетесь им в обществе других...
 Хотите сохранить хорошее зрение? Добавьте в рацион питания продукты, снижающие риск развития катаракты и глаукомы
Хотите сохранить хорошее зрение? Добавьте в рацион питания продукты, снижающие риск развития катаракты и глаукомы
 Общеизвестно, что морковь помогает улучшить зрение, но это не единственный овощ с подобными свойствами. Если речь идет о предотвращении катаракты...
Общеизвестно, что морковь помогает улучшить зрение, но это не единственный овощ с подобными свойствами. Если речь идет о предотвращении катаракты...
Лечение лихорадки у взрослых
Содержание

К ранее опубликованному на Tengrinews материалу об эпидемии Эболы (
К ранее опубликованному на Tengrinews материалу об эпидемии Эболы (
 ...
... 